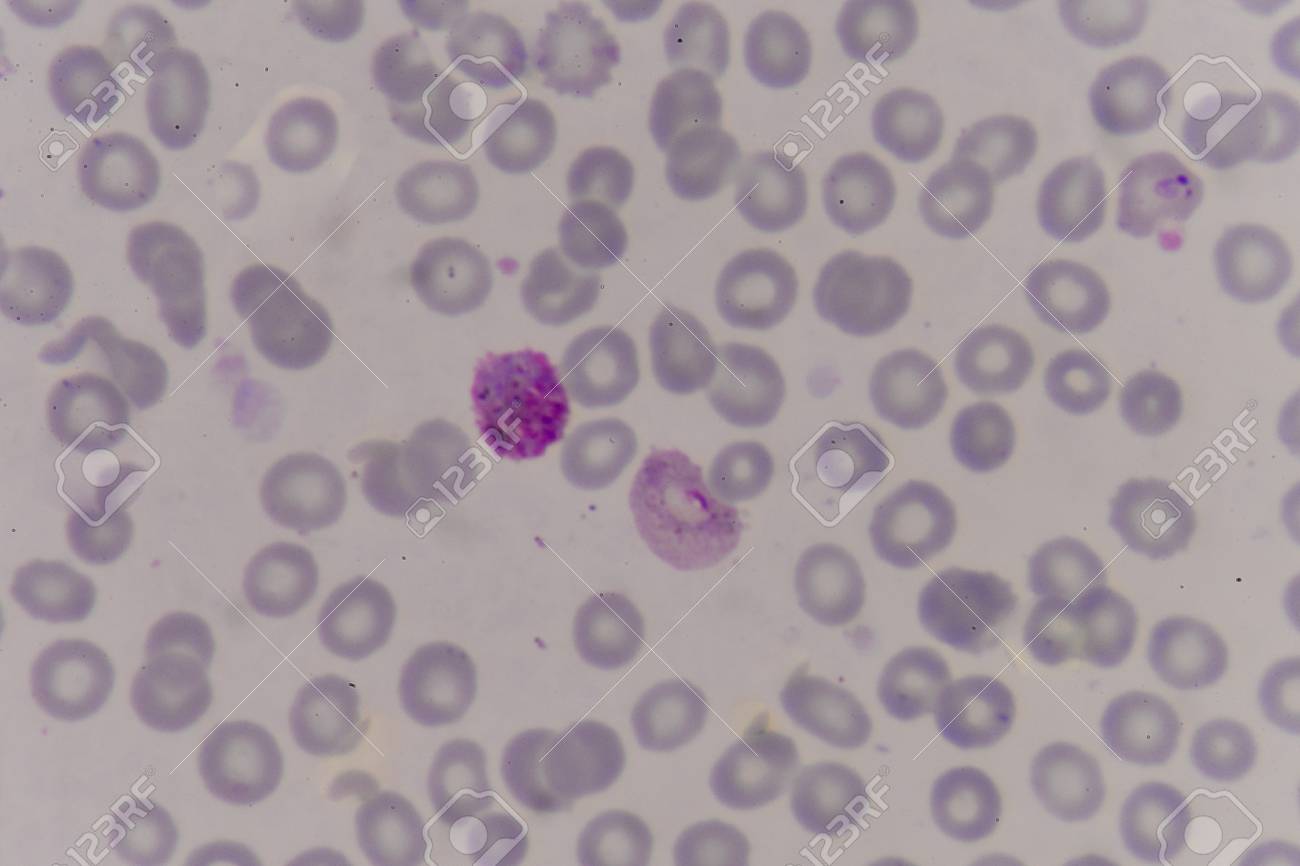
etiam-dictum-ipsum-a-felis

Download
Close
Автор:
id:
Ключевые слова:
agriculture, alpinia, antioxidant, asian, background, beauty, color, food, fresh, freshness, galanga, galangal, greater, green, health, healthy, herb, herbal, hot, ingredient, isolated, leaf, medical, natural, nature, organic, plant, raw, red, root, smell, spice, spicy, taste, thailand, treatment, up, vegetable, white, wood, yellow,





